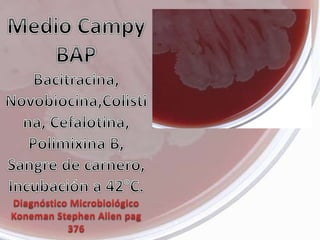
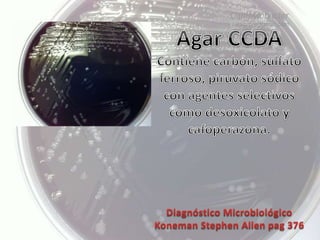
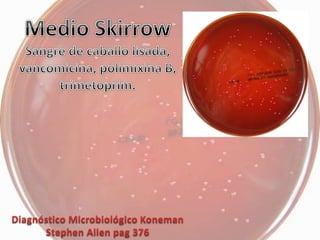
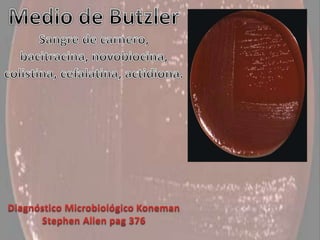

Campylobacter es un género de bacterias Gram negativas que incluye las especies C. jejuni y C. coli, las cuales son una causa importante de enteritis en humanos. Estas bacterias son móviles y de forma curva, y su infección se transmite principalmente por el consumo de alimentos o agua contaminados o contacto con animales infectados. La infección por Campylobacter causa diarrea aguda, dolor abdominal, fiebre y malestar general.